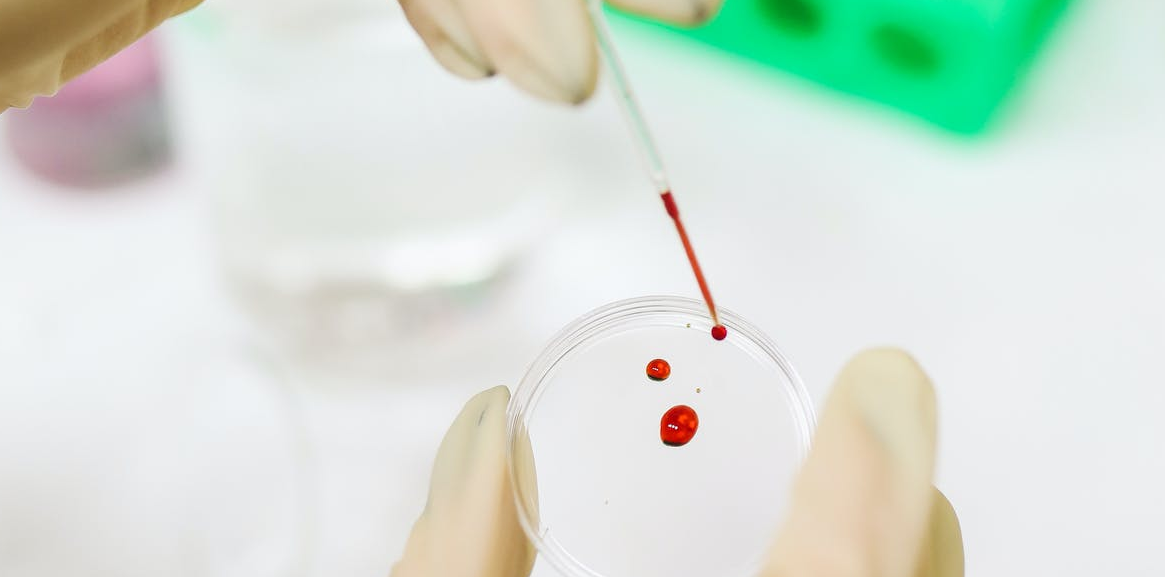

Πώς μία απλή εξέταση αίματος αποκαλύπτει πόσο κινδυνεύει ένας ασθενής με κορονοϊό
Σύμφωνα με Αμερικανούς επιστήμονες.
Έναν νέο απλό αιματολογικό δείκτη για την πρόγνωση του αυξημένου κινδύνου θανάτου ενός ασθενούς από τη νόσο Covid-19 προτείνουν Αμερικανοί επιστήμονες. Πρόκειται για το εύρος της κατανομής των ερυθρών αιμοσφαιρίων (RDW), το οποίο προκύπτει από μία απλή γενική εξέταση αίματος.
Οι ερευνητές της Ιατρικής Σχολής του Πανεπιστημίου Χάρβαρντ και του Γενικού Νοσοκομείου της Μασαχουσέτης, με επικεφαλής τον αναπληρωτή καθηγητή Βιολογίας και ερευνητή του Τμήματος Παθολογίας Τζον Χίγκινς, οι οποίοι έκαναν τη σχετική δημοσίευση στο αμερικανικό ιατρικό περιοδικό «JAMA Network Open», μελέτησαν στοιχεία για 1.641 ασθενείς που εισήχθησαν στο νοσοκομείο μετά από λοίμωξη από τον νέο κορωνοϊό SARS-CoV-2.
Διαπιστώθηκε ότι όσοι, κατά την εισαγωγή τους στο νοσοκομείο, είχαν τιμές εύρους κατανομής ερυθρών πάνω από το φυσιολογικό, είχαν κατά μέσο όρο σχεδόν τριπλάσιο κίνδυνο θανάτου, εμφανίζοντας τελικά ποσοστό θνητότητας 31%, έναντι 11% όσων ασθενών με Covid-19 που είχαν φυσιολογικά επίπεδα κατανομής ερυθρών. Πρόσθετη ήταν η αύξηση του κινδύνου θανάτου όσον αφορά τους ηλικιωμένους. Ενδεικτικά, το 46% των ασθενών άνω των 80 ετών με αυξημένα αρχικά επίπεδα RDW πέθαναν από Covid-19, έναντι 29% όσων είχαν κανονικά επίπεδα RDW.
Επιπροσθέτως, η περαιτέρω αύξηση του δείκτη RDW μετά την εισαγωγή στο νοσοκομείο σχετιζόταν με αύξηση της πιθανότητας θανάτου. Η θνητότητα όσων κατά την παραμονή τους στο νοσοκομείο εμφάνισαν άνοδο του RDW από φυσιολογικά σε αυξημένα επίπεδα ήταν 24%, έναντι 40% όσων εξ αρχής είχαν αυξημένα επίπεδα, τα οποία αυξήθηκαν κι άλλο όσο νοσηλεύονταν.
Το φυσιολογικό εύρος ερυθρών είναι 12,2% έως 16,1% στις γυναίκες και 11,8% έως 14,5% στους άνδρες. Οι ερευνητές εισηγούνται τη συνεχή παρακολούθηση του συγκεκριμένου δείκτη καθ’ όλη τη νοσηλεία, ώστε να εξάγονται συμπεράσματα κατά πόσο ένας ασθενής ανταποκρίνεται στη θεραπεία ή η υγεία του επιδεινώνεται. Διευκρίνισαν ότι το RDW δεν προορίζεται να αντικαταστήσει τα μοριακά τεστ ή αντισωμάτων για τον κορονοϊό, αλλά να βοηθήσει κυρίως τα νοσοκομεία να εντοπίζουν εκείνους τους ασθενείς με Covid-19 που πιθανότατα θα χρειαστούν εισαγωγή σε ΜΕΘ και διασωλήνωση.
Παράλληλα, οι επιστήμονες προσπαθούν να ανακαλύψουν τον βιολογικό μηχανισμό που προκαλεί τη μεγάλη αύξηση στο δείκτη RDW στις σοβαρές περιπτώσεις Covid-19. Προς το παρόν, δεν είναι βέβαιοι γιατί ορισμένοι ασθενείς έχουν αυξημένο RDW και άλλοι όχι.
Διαβάστε την επιστημονική δημοσίευση εδώ.
Πηγή: ΑΠΕ
